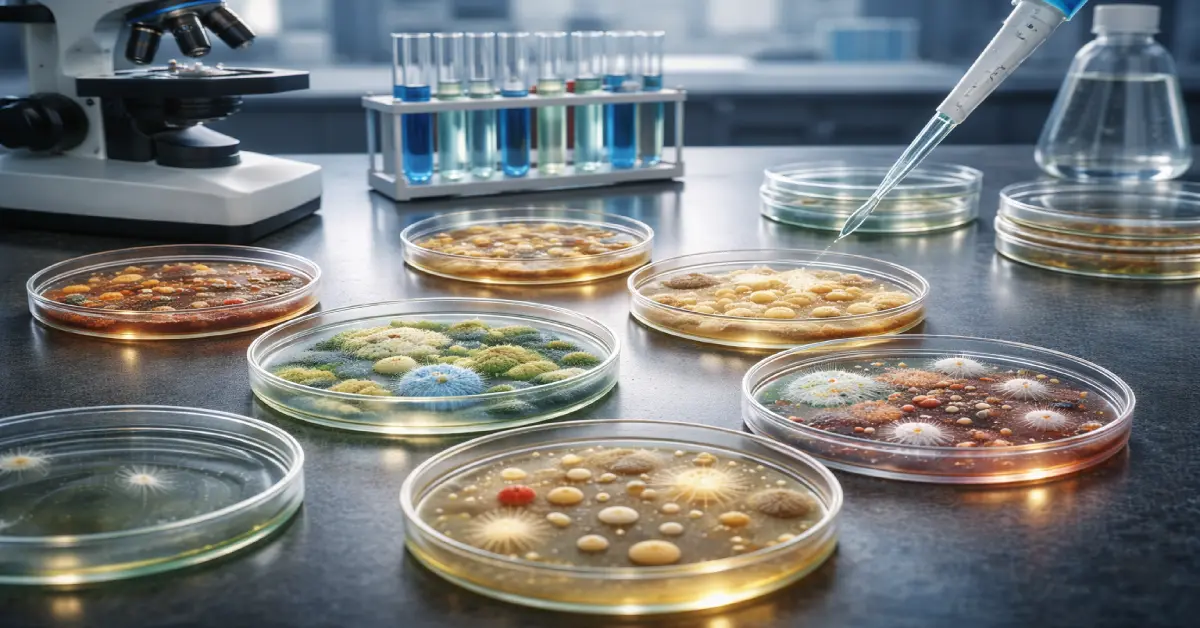
انواع آزمون های میکروبی

آزمون میکروبی چیست و چه چیزی را نشان میدهد | ۵ روش اصلی تشخیص آلودگی

چیزی که نمیبینید، لزوماً بیخطر نیست. بسیاری از مواد کاملاً سالم به نظر میرسند، در حالی که میتوانند حاوی حجم بالایی از آلودگی میکروبی نامرئی باشند؛ آلودگیای که بدون آزمون های میکروبی هرگز شناسایی نمیشود.
این آزمایشها تنها راه تشخیص واقعیت پنهان یک نمونه هستند و مشخص میکنند آنچه ایمن تصور میشود، واقعاً ایمن است یا یک خطر خاموش.
وقتی بدانید این آزمونها چگونه حقیقت را آشکار میکنند و نتایج آنها چه معنایی دارد، نگاه شما به مفهوم ایمنی و کیفیت برای همیشه تغییر خواهد کرد.
آزمون های میکروبی چیست و دقیقاً چه چیزی را بررسی میکند؟
تشخیص آلودگی همیشه با چشم ممکن نیست. نمونهای که کاملاً سالم به نظر میرسد، ممکن است در واقع آلوده باشد. تنها راه اطمینان، استفاده از آزمون های میکروبی است؛ روشهای علمی استانداردی که برای شناسایی میکروارگانیسمهای نامرئی و ارزیابی وضعیت بهداشتی نمونه بهکار میروند.
این آزمونها بر اساس استانداردهای بینالمللی طراحی شدهاند تا موجودات میکروسکوپی را شناسایی کنند؛ موجوداتی که میتوانند کیفیت، ایمنی و پایداری یک ماده را تحت تأثیر قرار دهند. این میکروارگانیسمها شامل گروههای مختلفی هستند، از جمله:
- باکتریها که در محیطهای مختلف مانند آب، خاک و سطوح رشد میکنند
- قارچها که میتوانند باعث تجزیه مواد و تغییر خواص آنها شوند
- مخمرها که در برخی شرایط موجب تغییرات شیمیایی و زیستی میشوند
- سایر میکروارگانیسمهای میکروسکوپی که ممکن است بر کیفیت و ایمنی تأثیر بگذارند
هدف این آزمایشها فقط تشخیص حضور میکروب نیست، بلکه بررسی دقیق ویژگیهای آنها نیز انجام میشود. بهطور علمی، این فرآیند سه جنبه اساسی را مشخص میکند:
- تعیین اینکه آیا میکروارگانیسمی وجود دارد یا خیر
- اندازهگیری تعداد دقیق میکروارگانیسمها در یک حجم مشخص از نمونه
- شناسایی نوع و ماهیت میکروارگانیسم برای درک بهتر تأثیر آن
نکتهای که این آزمایشها را بسیار مهم میکند این است که آلودگی میکروبی همیشه قابل مشاهده نیست. یک نمونه ممکن است از نظر ظاهری کاملاً طبیعی به نظر برسد، اما بررسیهای آزمایشگاهی نشان دهد که میکروارگانیسمها در حال رشد هستند. این واقعیت نشان میدهد که ارزیابی علمی، تنها روش قابل اعتماد برای تشخیص وضعیت واقعی یک نمونه است.

چرا آزمون های میکروبی اهمیت حیاتی دارند؟
میکروارگانیسمها بخشی طبیعی از محیط اطراف ما هستند، اما حضور کنترلنشده آنها میتواند بهطور مستقیم بر ایمنی و کیفیت یک ماده تأثیر بگذارد. نکته مهم این است که آلودگی میکروبی معمولاً هیچ نشانه ظاهری مشخصی ایجاد نمیکند. یعنی یک ماده ممکن است کاملاً سالم به نظر برسد، اما در واقع حاوی میکروارگانیسمهای فعال باشد.
بر اساس اصول علمی میکروبیولوژی و استانداردهای بینالمللی، آزمون های میکروبی برای جلوگیری از خطرات پنهان و اطمینان از وضعیت واقعی نمونه انجام میشوند.
مهمترین دلایل انجام این آزمایشها شامل موارد زیر است:
- حفاظت از سلامت انسان
برخی باکتریها مانند سالمونلا و اشریشیا کلی میتوانند باعث عفونت و بیماری شوند. شناسایی این میکروارگانیسمها نقش مهمی در جلوگیری از انتقال عوامل بیماریزا دارد. - اطمینان از کنترل کیفیت مواد غذایی
رشد میکروارگانیسمها میتواند باعث تغییر در ساختار، ترکیب و ویژگیهای یک ماده شود. این تغییرات ممکن است عملکرد یا ایمنی آن را کاهش دهد. - تعیین پایداری و زمان نگهداری
میزان آلودگی میکروبی یکی از عوامل اصلی در تعیین مدت زمان قابل نگهداری یک ماده است. هرچه تعداد میکروارگانیسمها کمتر باشد، پایداری بیشتر خواهد بود. - رعایت الزامات ایمنی جهانی
سازمانهایی مانند سازمان جهانی بهداشت تأکید میکنند که ارزیابی میکروبی یکی از پایههای اصلی تضمین ایمنی در مواد مرتبط با سلامت انسان است. - جلوگیری از تخریب و خسارت
تشخیص زودهنگام آلودگی کمک میکند از گسترش میکروارگانیسمها و آسیب گسترده به مواد جلوگیری شود.
در واقع، این آزمایشها تنها راه علمی برای تشخیص آلودگی نامرئی هستند و نقش اساسی در حفظ ایمنی، کیفیت و قابلیت استفاده از مواد مختلف دارند.
انواع آزمون های میکروبی و هدف هر کدام
آزمون های میکروبی بر اساس هدف، نوع نمونه و نوع اطلاعاتی که ارائه میدهند، به چند دسته اصلی تقسیم میشوند و هر یک بخشی از وضعیت بهداشتی، ایمنی و کیفیت نمونه را مشخص میکنند. در ادامه، مهمترین انواع این آزمون ها بهصورت واضح توضیح داده شدهاند.
1. شمارش کل میکروارگانیسمها
یکی از پایهایترین و مهمترین آزمون های میکروبی، آزمون شمارش کل میکروارگانیسمها است. هدف این آزمون، تعیین تعداد کل میکروارگانیسمهای زنده موجود در یک نمونه است. این آزمایش مشخص نمیکند که چه نوع میکروبی وجود دارد، بلکه فقط تعداد کل آنها را اندازهگیری میکند.
نتیجه این آزمون معمولاً به صورت CFU گزارش میشود، که به معنی تعداد کلنیهای میکروبی است که در شرایط آزمایشگاهی رشد کردهاند. هر کلنی نشاندهنده وجود یک یا چند میکروارگانیسم زنده در نمونه اولیه است.
این آزمون اطلاعات بسیار مهمی ارائه میدهد، از جمله:
- میزان آلودگی کلی نمونه
- سطح کیفیت بهداشتی
- میزان ایمنی نمونه برای استفاده یا مصرف
هرچه عدد CFU کمتر باشد، نشاندهنده تمیزی بیشتر، کیفیت بالاتر و شرایط بهداشتی بهتر است. در مقابل، عدد بالا میتواند نشاندهنده آلودگی زیاد، نگهداری نامناسب یا کاهش کیفیت باشد. این آزمون در صنایع غذایی، دارویی، آرایشی، تجهیزات پزشکی و بررسی کیفیت آب کاربرد گستردهای دارد.
2. آزمون استریلیتی
آزمون استریلیتی یکی از حساسترین و حیاتیترین آزمون های میکروبی است که مشخص میکند آیا یک نمونه کاملاً عاری از هرگونه میکروارگانیسم زنده است یا خیر. برخلاف آزمون شمارش میکروبی که تعداد را اندازهگیری میکند، هدف این آزمون بررسی وجود یا عدم وجود هر نوع آلودگی میکروبی است.
در این آزمون، نمونه در شرایط کاملاً کنترلشده در محیطهای کشت مخصوص قرار داده میشود و برای مدت مشخصی تحت نظر قرار میگیرد. اگر هیچ رشد میکروبی مشاهده نشود، نمونه استریل در نظر گرفته میشود. اما اگر حتی مقدار بسیار کمی میکروارگانیسم رشد کند، نمونه غیراستریل محسوب میشود.
این آزمون اهمیت حیاتی در موارد زیر دارد:
- داروهای تزریقی، زیرا ورود میکروب به بدن میتواند خطرناک باشد
- تجهیزات پزشکی مانند سرنگ، ایمپلنت و ابزار جراحی
- محصولات حساس که باید کاملاً عاری از آلودگی باشند
3. آزمون شناسایی پاتوژنها
این نوع از آزمون های میکروبی برای شناسایی میکروارگانیسمهای بیماریزا یا پاتوژن انجام میشود. پاتوژنها میکروارگانیسمهایی هستند که میتوانند باعث بیماری، عفونت یا خطرات جدی برای سلامت انسان شوند.
هدف این آزمون فقط شمارش نیست، بلکه تشخیص دقیق نوع میکروارگانیسم خطرناک است. حتی اگر تعداد این میکروبها کم باشد، وجود آنها میتواند خطرناک باشد.
برخی از مهمترین پاتوژنهایی که در این آزمون بررسی میشوند عبارتند از:
- سالمونلا (عامل مسمومیت غذایی)
- استافیلوکوکوس (عامل عفونتهای مختلف)
- لیستریا (عامل عفونتهای خطرناک، بهویژه در افراد آسیبپذیر)
وجود هر یک از این میکروارگانیسمها میتواند نشاندهنده آلودگی خطرناک باشد و ممکن است استفاده از محصول را غیرایمن کند.
4. آزمون کپک و مخمر
آزمون کپک و مخمر یکی دیگر از مهمترین آزمون های میکروبی است که برای شناسایی و اندازهگیری قارچها و مخمرها در نمونه انجام میشود. این میکروارگانیسمها ممکن است همیشه بیماریزا نباشند، اما میتوانند باعث کاهش کیفیت و فساد محصولات شوند.
وجود کپک و مخمر میتواند منجر به مشکلات زیر شود:
- فساد و خراب شدن مواد
- ایجاد بوی نامطبوع
- تغییر در ظاهر محصول
- کاهش کیفیت و ماندگاری
این آزمون بهویژه در صنایع غذایی، محصولات آرایشی و دارویی اهمیت زیادی دارد، زیرا وجود این میکروارگانیسمها میتواند کیفیت محصول را بهمرور کاهش دهد و آن را غیرقابل استفاده کند.
5. آزمون اندوتوکسین
آزمون اندوتوکسین یکی از تخصصیترین آزمون های میکروبی است که برای شناسایی سمومی به نام اندوتوکسین انجام میشود. اندوتوکسینها موادی سمی هستند که توسط برخی باکتریها تولید میشوند و حتی اگر خود باکتری از بین رفته باشد، این سموم ممکن است همچنان باقی بمانند.
وجود اندوتوکسین در محصولات پزشکی میتواند باعث واکنشهای خطرناک در بدن شود، از جمله:
- تب
- التهاب
- واکنشهای ایمنی شدید
این آزمون اهمیت ویژهای در موارد زیر دارد:
- داروهای تزریقی
- سرمها و واکسنها
- تجهیزات پزشکی که با خون تماس دارند
هدف این آزمون اطمینان از ایمنی کامل محصولات پزشکی و جلوگیری از ورود سموم خطرناک به بدن است.

مراحل انجام آزمون های میکروبی در آزمایشگاه تخصصی
انجام آزمون های میکروبی یک فرآیند مرحلهبهمرحله و کاملاً کنترلشده است. هدف این فرآیند، بررسی دقیق وجود میکروارگانیسمها بدون ایجاد خطا یا آلودگی اضافی است. در هر مرحله، شرایط خاصی رعایت میشود تا نتیجه نهایی واقعی و قابل اعتماد باشد.
مرحله ۱: نمونهبرداری؛ شروع با یک نمونه واقعی و بدون آلودگی
در این مرحله، مقدار مشخصی از ماده مورد نظر برداشته میشود. این نمونه میتواند از محصول، آب، سطح تجهیزات یا هر ماده دیگری باشد.
شرایط مهم این مرحله:
- استفاده از ظرف استریل
- استفاده از ابزار استریل
- جلوگیری از تماس نمونه با دست یا محیط
- بسته شدن فوری ظرف پس از نمونهبرداری
چه اتفاقی در این مرحله میافتد:
- نمونه واقعی برای آزمایش جدا میشود
- از ورود میکروبهای محیط جلوگیری میشود
اگر این مرحله درست انجام نشود:
- آلودگی خارجی وارد نمونه میشود
- نتیجه آزمون های میکروبی غیرواقعی میشود
مرحله ۲: انتقال نمونه؛ حفظ شرایط واقعی تا آزمایشگاه
پس از نمونهبرداری، نمونه باید سریع و در شرایط مناسب به آزمایشگاه منتقل شود.
شرایط مهم انتقال:
- دمای کنترلشده
- انتقال در کوتاهترین زمان ممکن
- استفاده از ظروف بسته و مناسب
- جلوگیری از گرما یا سرمای شدید
چه اتفاقی در این مرحله میافتد:
- وضعیت میکروارگانیسمها بدون تغییر باقی میماند
- از رشد یا مرگ میکروبها قبل از آزمایش جلوگیری میشود
هدف این مرحله
- حفظ وضعیت واقعی نمونه
مرحله ۳: آمادهسازی محیط کشت؛ فراهم کردن محل رشد میکروبها
در این مرحله، نمونه روی مادهای مخصوص به نام محیط کشت قرار میگیرد. این محیط دارای مواد غذایی لازم برای رشد میکروارگانیسمها است.
ویژگیهای محیط کشت:
- کاملاً استریل
- دارای مواد مغذی
- مناسب برای رشد میکروارگانیسمها
چه اتفاقی در این مرحله میافتد:
- اگر میکروارگانیسم در نمونه وجود داشته باشد، آماده رشد میشود
هدف این مرحله:
- قابل مشاهده شدن میکروارگانیسمها
مرحله ۴: انکوباسیون؛ ایجاد شرایط مناسب برای رشد
در این مرحله، نمونه داخل دستگاهی به نام انکوباتور قرار داده میشود.
شرایط این مرحله:
- دمای کنترلشده
- معمولاً بین ۳۰ تا ۳۷ درجه سانتیگراد
- زمان مشخص برای رشد
چه اتفاقی در این مرحله میافتد:
- میکروارگانیسمها شروع به رشد میکنند
- کلنیهای قابل مشاهده تشکیل میشود
هدف این مرحله:
- آماده شدن نمونه برای بررسی در آزمون های میکروبی
مرحله ۵: شمارش و بررسی؛ تعیین میزان و نوع آلودگی
پس از رشد کامل، میکروارگانیسمها بررسی میشوند.
چه اتفاقی در این مرحله میافتد:
- کلنیها شمارش میشوند
- میزان آلودگی مشخص میشود
- در صورت نیاز، نوع میکروارگانیسم شناسایی میشود
نتیجه نهایی مشخص میکند:
- سطح آلودگی نمونه
- ایمن یا آلوده بودن نمونه
- کیفیت بهداشتی نمونه
💡 این مرحله، نتیجه نهایی و واقعی آزمایش را مشخص میکند.
تجهیزات مورد استفاده در آزمایشگاه تخصصی میکروبیولوژی
در آزمایشگاه تخصصی، هر تجهیز نقش مشخصی در جلوگیری از آلودگی، رشد میکروارگانیسمها و بررسی دقیق نمونه دارد. جدول زیر مهمترین تجهیزات، کاربرد آنها و نقش هر کدام در دقت آزمون را نشان میدهد.

استانداردهای بینالمللی مرتبط با آزمون های میکروبی
آزمون های میکروبی باید مطابق استانداردهای بینالمللی انجام شوند تا نتایج دقیق، قابل اعتماد و مورد پذیرش جهانی باشند. این استانداردها روش انجام آزمایش، شرایط بررسی نمونه و نحوه گزارش نتایج را مشخص میکنند.
استاندارد ایزو (ISO)
تدوین شده توسط سازمان بینالمللی استانداردسازی
این استاندارد روشهای انجام آزمایش، شرایط نمونهبرداری و نحوه شناسایی میکروارگانیسمها را مشخص میکند. هدف آن ایجاد نتایج دقیق و قابل مقایسه در تمام آزمایشگاههای جهان است.
استاندارد آستم (ASTM)
ارائه شده توسط انجمن آزمون و مواد آمریکا
این استاندارد روشهای دقیق انجام آزمایشهای میکروبی و نحوه بررسی آلودگی را مشخص میکند. هدف آن افزایش دقت، صحت و قابلیت اطمینان نتایج آزمایش است.
استاندارد سازمان غذا و داروی آمریکا (FDA)
تدوین شده توسط سازمان غذا و داروی آمریکا
این استاندارد الزامات ایمنی میکروبی برای مواد غذایی، داروها و تجهیزات پزشکی را مشخص میکند. هدف آن محافظت از سلامت انسان و جلوگیری از خطرات ناشی از آلودگی میکروبی است.
کاربرد آزمون های میکروبی در صنایع مختلف
آزمون های میکروبی نقش اساسی در بررسی ایمنی، کیفیت و سلامت محصولات در صنایع مختلف دارند. هدف اصلی این آزمونها، شناسایی آلودگیهای میکروبی و جلوگیری از خطرات بهداشتی و کاهش کیفیت است.
مهمترین کاربردها عبارتاند از:
صنایع غذایی
بررسی وجود باکتریها، کپکها و سایر میکروارگانیسمها در مواد غذایی. این آزمونها برای جلوگیری از فساد، افزایش ایمنی مصرف و تعیین ماندگاری محصول انجام میشوند.
صنایع دارویی
کنترل استریل بودن داروها و بررسی عدم وجود میکروارگانیسمهای خطرناک. این موضوع برای جلوگیری از انتقال عفونت و تضمین ایمنی مصرف دارو ضروری است.
صنایع آب و آشامیدنی
بررسی کیفیت میکروبی آب و شناسایی آلودگیهای احتمالی. این آزمونها برای اطمینان از سلامت آب و جلوگیری از انتقال بیماریها اهمیت دارند.
صنایع آرایشی و بهداشتی
کنترل آلودگی میکروبی در محصولات آرایشی. وجود میکروارگانیسمها میتواند باعث فساد محصول و ایجاد خطر برای مصرفکننده شود.
صنایع نفت و انرژی
شناسایی میکروارگانیسمهایی که میتوانند باعث خوردگی تجهیزات و کاهش کیفیت مواد شوند. این آزمونها برای حفظ ایمنی و عملکرد تجهیزات اهمیت دارند.
نحوه تفسیر نتایج آزمون های میکروبی
نتایج آزمون های میکروبی نشان میدهند نمونه از نظر آلودگی میکروبی در چه وضعیتی قرار دارد و آیا از نظر بهداشتی ایمن است یا خطر آلودگی وجود دارد. این نتایج معمولاً در سه سطح اصلی طبقهبندی میشوند:

❓سوالات متداول درباره آزمون های میکروبی
1️⃣ آیا آزمون های میکروبی فقط برای حوزه پزشکی استفاده میشوند؟
خیر. این آزمونها در صنایع غذایی، دارویی، آب، آرایشی، نفت و بسیاری از حوزههای صنعتی برای بررسی آلودگی و کنترل کیفیت استفاده میشوند.
2️⃣ انجام آزمون های میکروبی چقدر زمان میبرد؟
بسته به نوع آزمایش، معمولاً بین ۱ تا ۷ روز زمان نیاز است. برخی آزمونها سریعتر و برخی برای رشد کامل میکروارگانیسمها به زمان بیشتری نیاز دارند.
3️⃣ آیا امکان خطا در نتایج این آزمایش وجود دارد؟
در صورت رعایت استانداردها، استفاده از تجهیزات استریل و انجام صحیح مراحل آزمایش، احتمال خطا بسیار کم است. خطا معمولاً به دلیل نمونهبرداری یا شرایط نامناسب رخ میدهد.
4️⃣ چرا نمونهبرداری در این آزمایش اهمیت زیادی دارد؟
زیرا نمونهبرداری نادرست میتواند باعث ورود آلودگی خارجی یا از بین رفتن میکروارگانیسمها شود و نتیجه واقعی را تغییر دهد.
5️⃣ آیا تمام میکروارگانیسمها با این آزمایش قابل شناسایی هستند؟
بیشتر میکروارگانیسمهای مهم و خطرناک با روشهای استاندارد قابل شناسایی هستند، بهویژه آنهایی که بر ایمنی، کیفیت و سلامت تأثیر میگذارند.
نتیجهگیری؛ واقعیتی که همیشه پنهان میماند
بسیاری از آلودگیهای میکروبی هیچ نشانه ظاهری ندارند، اما میتوانند کیفیت، ایمنی و سلامت یک ماده را بهطور جدی تحت تأثیر قرار دهند. تنها راه شناسایی دقیق این آلودگیهای نامرئی، انجام آزمون های میکروبی و بررسی علمی نتایج آنها است. این آزمایشها تصویری واقعی از وضعیت بهداشتی و سطح ایمنی هر نمونه ارائه میدهند.
درک نحوه انجام این آزمونها و تفسیر نتایج آنها، دیدی دقیقتر و آگاهانهتر ایجاد میکند. اگر پرسشی در ذهن دارید یا تجربهای در این زمینه داشتهاید، مطرح کردن آن میتواند به درک بهتر این فرآیند علمی و روشن شدن نکات مهم کمک کند.
منابع:

